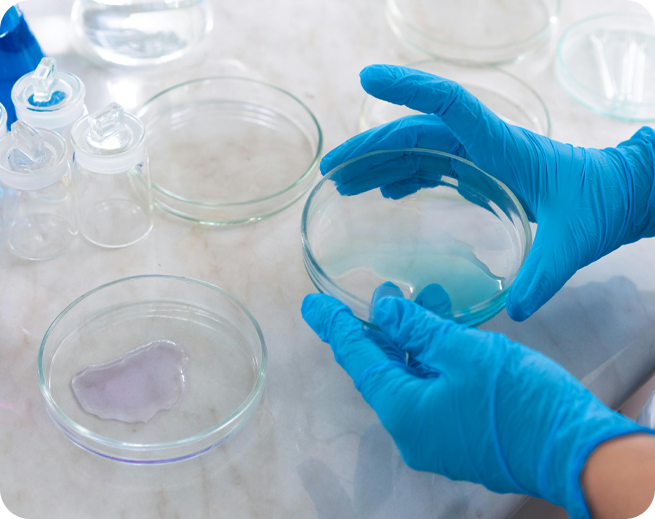

Contact Alphalabs
Have a question about our products or your order? Contact us today!

Our Location
10260 NW 47th St. Sunrise, FL 33351

Call/Text (Monday-Friday 10am-5pm)
754-330-4267

Email address
Help@GoAlphaLabs.com

Get in touch with us
The Alpha Labs Difference
At Alpha Labs, we’re committed to pushing the boundaries of scientific research by providing premium-quality research peptides you can trust. All our products are third party tested under strict quality standards, ensuring consistency, reliability, and integrity in every vial. With fast shipping, secure packaging, and a commitment to excellence, GoAlphaLabs.com is your dependable partner for advanced research needs.